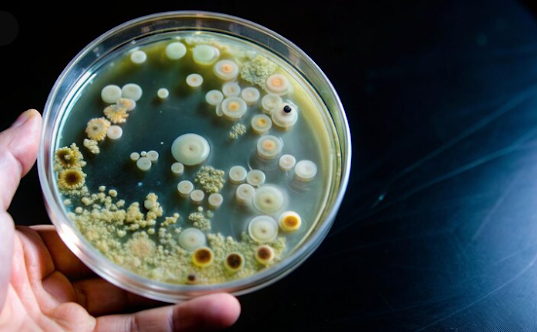

How Protein G Magnetic Beads Facilitate Advanced Antibody Purification
Protein G magnetic beads have revolutionized the field of antibody purification, offering a highly efficient and advanced method for isolating antibodies from complex biological samples. When coupled with lytic solutions, these magnetic beads provide a powerful tool for researchers and biotechnologists seeking to streamline their purification processes. In this article, we will delve into the intricate workings of Protein G magnetic beads and explore how they facilitate the purification of antibodies with unprecedented speed and precision. Additionally, we will examine the role of lytic solutions in enhancing the efficacy of antibody purification, compare this innovative approach with traditional methods, and highlight the myriad applications and benefits of utilizing Protein G magnetic beads in antibody purification workflows.
  Overview of Protein G Magnetic Beads
Protein G magnetic beads are like the cool kids of the
antibody purification world – magnetic, efficient, and trendy. They're tiny
beads coated with Protein G, a protein that has a magnetic personality
(literally) and a knack for grabbing onto antibodies like a magnet to metal.
Importance in Antibody Purification Processes
These beads are the secret sauce that makes antibody
purification a breeze. By latching onto antibodies in a solution, they help to
separate the good stuff from the not-so-good stuff, making the purification
process smoother than a jazz saxophonist on a Saturday night.
The Role of Lytic Solutions in Antibody Purification
Lytic solutions are like the tough guys who break down cell walls and release all the good stuff inside – in this case, the antibodies we're after. They're like the Hulk of the purification world, smashing through obstacles and making our lives easier.
  Benefits of Lytic Solutions in Antibody Purification
Using lytic solutions in antibody purification is like
having a cheat code for efficiency. They help to release antibodies from cells,
making the purification process quicker and more effective. It's like a
shortcut to antibody heaven.
Enhanced Efficiency of Antibody Purification with Protein G Magnetic Beads
Protein G magnetic beads work their magic by selectively binding to antibodies, like a magnet drawn to its metal counterpart. This selective affinity helps to capture the antibodies efficiently, leaving the rest of the unwanted molecules in the dust.
  Improving Purification Yield and Purity
With Protein G magnetic beads in the mix, antibody
purification reaches new heights of yield and purity. They help to increase the
amount of purified antibodies obtained and ensure that the final product is as
pure as a mountain stream, minus the rocks.
Comparison with Traditional Antibody Purification Methods
Traditional antibody purification methods can be like trying to find a needle in a haystack – time-consuming, labor-intensive, and often yielding less-than-stellar results. It's like looking for a unicorn in a sea of donkeys.
  Advantages of Protein G Magnetic Beads over Traditional
Techniques
Protein G magnetic beads swoop in like a superhero to save
the day, offering a faster, more efficient, and effective alternative to
traditional methods. They make antibody purification a walk in the park
compared to the uphill battle of old-school techniques.
Applications and Benefits of Using Protein G Magnetic Beads
Protein G magnetic beads are like the Swiss Army knife of biomedical research—they can be used for various purposes, from isolating antibodies to studying protein interactions. Whether you're exploring cancer therapies or investigating infectious diseases, these beads are your trusty sidekick.
Benefits of Protein G Magnetic Beads in Antibody Purification
Say goodbye to the days of tedious antibody purification! Protein G magnetic beads swoop in like superheroes, binding specifically to antibodies and separating them from the rest of the molecular noise. Not only do they work quickly and efficiently, but they also ensure high purity and yield, making your research life a whole lot easier.
Best Practices for Utilizing Protein G Magnetic Beads in Antibody Purification
Think of bead concentrations as your secret sauce—getting the right balance ensures optimal antibody binding and purification. Experiment with different conditions like pH and buffer composition to find the sweet spot that maximizes efficiency and results.
Ensuring Reproducibility and Consistency
Consistency is key in the world of research. To avoid any "oops" moments, maintain detailed protocols, standardize procedures, and QC like a boss. By keeping your methods on point, you'll be the antibody purification maestro in no time.
Successful Antibody Purification Using Protein G Magnetic Beads
Application in Immunology Research
In the realm of immunology, where precision is paramount, Protein G magnetic beads shine. Researchers have successfully purified specific antibodies for studying immune responses and developing targeted therapies, paving the way for ground-breaking discoveries in the field.
Industrial Scale Antibody Production
Picture this: a bustling antibody production facility running smoothly like a well-oiled machine. With Protein G magnetic beads in the mix, large-scale purification becomes a breeze, ensuring high yields and consistent quality for commercial antibody production that's as reliable as your morning coffee.
Future Developments and Trends in Antibody Purification Technologies
The world of antibody purification is evolving faster than you can say "Protein G magnetic beads." From novel chromatography techniques to cutting-edge automation, researchers are exploring new avenues to streamline purification workflows and push the boundaries of antibody research.
Potential Innovations in Protein G Magnetic Beads Technology
Hold onto your lab coats—could Protein G magnetic beads get even better? With ongoing research and innovation, we might see enhancements like increased binding capacities, faster processing times, or customizable functionalities. The future looks bright for these trusty beads!
In conclusion, the combination of Protein G magnetic beads and lytic solutions represents a cutting-edge solution for advancing antibody purification techniques. By optimizing efficiency, yield, and purity, these innovative technologies pave the way for breakthroughs in biomedical research, biopharmaceutical development, and beyond. As the landscape of antibody purification continues to evolve, the integration of Protein G magnetic beads and lytic solutions holds promise for shaping the future of antibody production and discovery.
Comments
Post a Comment